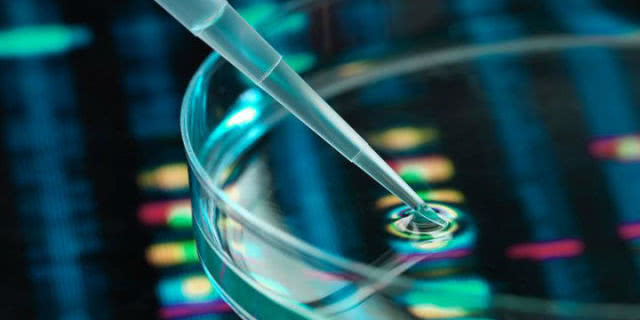

国内生物医药领域“独角兽”企业——复宏汉霖松江生物医药产业化基地今天开工建设,标志着长三角G60科创走廊生物医药产业又落下重要的一颗棋子,这片位于上海市松江区西部科技园区的200亩土地上将崛起一座低碳、节能、环保的现代化智能生物医药基地。
作为上海生物医药领域“独角兽”企业,截至目前,复宏汉霖13个产品、2个联合治疗方案已完成23项适应症的临床试验申请,累计获得全球范围内29个临床试验许可。其中,公司首款重磅产品汉利康(利妥昔单抗注射液)已获国家药监局新药上市注册批准,成为中国首个获批上市的生物类似药,价格为原研药的70%。松江基地是复宏汉霖在上海建立的第二个产业基地,也是该公司历经十年研发转向大规模生产的开始。
复宏汉霖总裁兼首席执行官刘世高表示,基地兼具研发和生产两大功能,未来将满足20到30个产品全球销售的产能需求,其中包括5到10个生物类似药产品,10到20个创新药产品,主要用于肿瘤等疾病的治疗。之所以选择松江,是因为其在长三角中具有枢纽地位,复宏汉霖希望能依托松江基地,与长三角优质生物医药企业建立技术研发、生产销售方面的合作。

生物医药产业是上海市战略性新兴产业的重要支柱,松江是上海生物医药产业基地之一。松江已集聚生物医药重点企业近百家。2018年,松江规模以上生物医药企业实现制造业产值同比增长19.3%。
据松江区科委相关负责人介绍,松江生物医药产业空间布局不断优化,龙头、骨干企业快速集聚,仅去年就引进11个生物医药产业化项目,合计总投资328亿元。临港松江科技城生命健康产业园瞄准精准医疗、精密医疗器械、医疗服务平台等细分领域,目前已集聚相关企业80余家。九亭生命健康科技园坚持规划引领,正在推进修正药业、复旦科技园、亿帆医药、四方药业等项目落地。G60脑智科创基地是中科院与市政府共建的科创基地,目标是建成国际非人灵长类疾病模型研发中心、国家级脑智技术研究及成果转化中心、长三角创新药物研发及智能技术产业辐射源点。
目前松江生物医药企业涵盖15个行业,每个领域都有龙头企业布局,比如生物制药领域的复宏汉霖、修正药业,生物制品领域的坦泰生物、万力华,医疗服务领域的新开源,医疗器械领域的易固医疗,医疗设备领域的碧云天,医用可吸收生物材料领域的昊海生物等。
上海市生物医药科技产业促进中心主任傳大煦表示,松江作为上海生物医药产业基地之一,主要聚焦创新药物研发、高端医疗器械、人工智能在医疗中的应用等领域,其优越的地理位置,把上海生物医药的未来空间打开了。复宏汉霖松江生物医药产业化基地开工,标志着松江生物医药产业进入了快速发展的阶段。松江是长三角G60科创走廊的策源地,生物医药产业快速发展将为长三角生物医药产业联动发挥更大作用。
作者:沈湫莎
编辑:张鹏
责任编辑:唐闻佳
*文汇独家稿件,转载请注明出处。